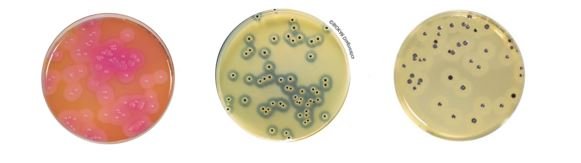
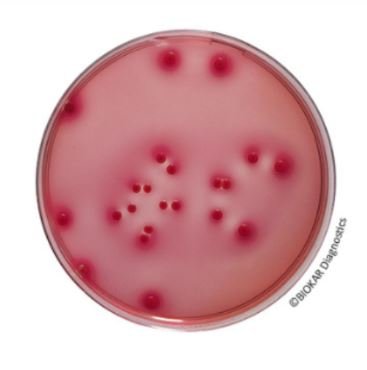
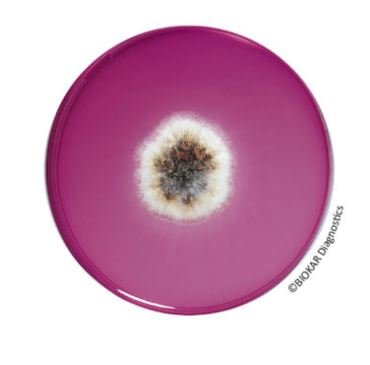
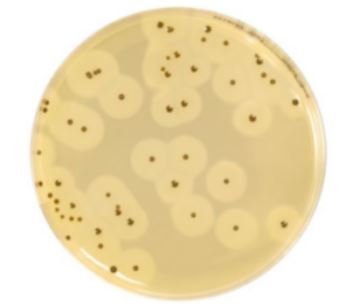
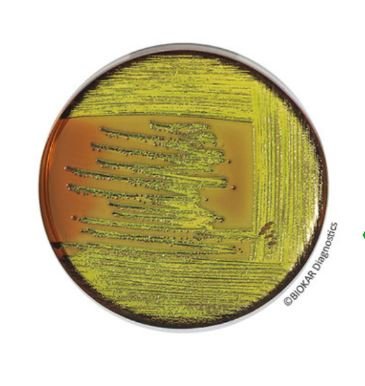
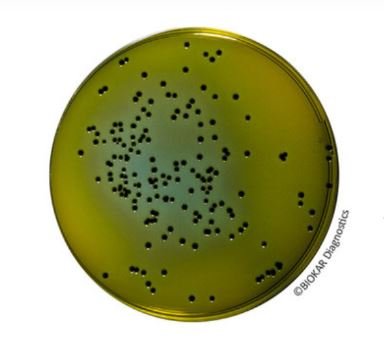
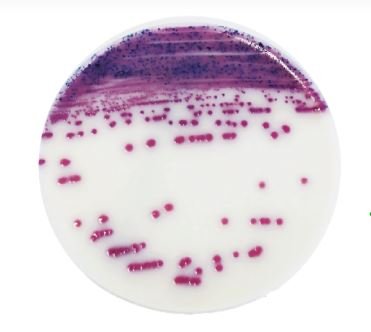
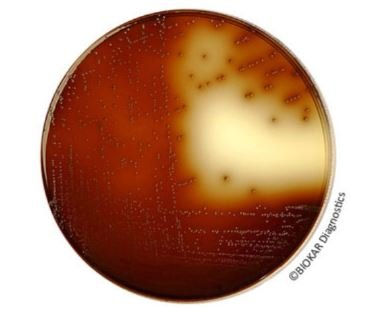
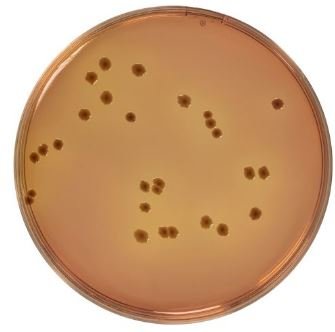

Food
- Animal Health
- Cosmetic
- Food
- Rapid methods
- Water and environments
- Presentation
- Microorganism
Desoxycholate (0,1 %) Lactose Agar

Desoxycholate (0.1%) Lactose Agar is a selective medium for the enumeration of coliform bacteria in milk, dairy products and other food products. The medium is also recommended for the isolation and culture of Shigella.
Packaging
Dehydrated medium :
BK062HA – 500 g bottle
Desoxycholate Lactose Agar
Desoxycholate Lactose Agar is a selective medium for the enumeration of coliform bacteria in water, milk, dairy and other food products. The medium is also used for the differentiation and isolation of enterobacteria from samples of animal origin.
Packaging
Dehydrated medium :
BK065HA – 500 g bottle
Dichloran Rose Bengal Chloramphenicol (DRBC) Agar
Dichloran Rose Bengal Chloramphenicol agar is recommended for the enumeration of viable yeasts and molds that develop in products destined for human and animal consumption with a water activity (aw) greater than 0.95.
The media does not allow for the enumeration of mold spores.
Packaging
Ready-to-melt medium :
BM14208 – 10 vials of 200 L
Dehydrated medium:
BK198HA – 500 g bottle
Dichloran-Glycerol (DG 18) Agar

Dichloran-glycerol (DG-18) agar is recommended for the enumeration of yeasts and molds that develop in products with a low water activity (aw less than 0.95). The media finds particular applications for the enumeration and isolation of xerophilic molds which may be found in dehydrated or extremely dry products, such as heavily sugared or salted foods, dried fruits, cereals, cakes and cookies, flour and meat or fish based dehydrated products. The media favors a controlled growth regarding the size and breadth of mold mycelia and yeast colonies, allowing easier and more accurate counts.
Packaging
Ready-to-melt medium (with glycerol):
BM10908 – 10 vials of 100 mL
Dehydrated medium (without glycerol):
BK170HA – 500 g bottle
Dipotassium Hydrogenphosphate Solution
Dipotassium hydrogenphosphate solution is a diluent used to prepare dispersion solutions for the microbiological control of cheese, roller-dried milk, fermented milk, caseinates, dried acid whey, and sour cream.
The typical composition corresponds to that defined in ISO 6887-5 standard.
Packaging
Ready-to-use medium:
BM19308 – 2 flexible bags of 5 L
Drigalski Lactose Agar

Drigalski Lactose agar is used for the selective isolation of Enterobacteriaceae. It allows the differentiation of bacteria according to their ability to ferment lactose in food, pharmaceutical, cosmetic and veterinary samples.
Packaging
Dehydrated medium :
BK036HA – 500 g bottle
Easy Staph Agar®
EASY STAPH is an alternative method for the enumeration of coagulase positive Staphylococci in food products, in animal feeds and in environmental samples. Devoid of the need for confirmation, the method allows count of pathogenic staphylococci in 22 hours instead of the usual 48 hours in the case of the standardized method NF EN ISO 6888-2. The media support the use of surface inoculation, in depth or by the Spiral method.
For all products destined for human consumption, the method is certified NF VALIDATION, under the Attestation N°BKR 23/10 – 12/15.
Packaging
EASY STAPH ready-to-use :
BM18708 – 20 Petri plates Ø 90 mm
BM19008 – 120 Petri plates Ø 90 mm
EASY STAPH supplement :
BS09008 – 8 vials qsf 100 mL
BS09708- 1 vial qsf 500 mL
EASY STAPH KIT :
BT01208 – 6 vials of 190 mL of base media + 6 freeze-dried supplements
BT01308 – 6 vials of 90 mL of base media + 6 freeze-dried supplements
EC Broth

EC Broth (abbreviation for E. coli) is a selective media used for the confirmation of E. coli in water, milk and other food products, as well as live shellfish.
The typical composition of the broth responds to that defined in the normalized method of presumptive E. coli enumeration.
Packaging
Dehydrated medium:
BK162HA – 500 g bottle
EE Broth Acc. To Mossel

EE Broth, buffered and containing bile salts, brilliant green and glucose, proposed by Mossel, is a selective enrichment media for the enumeration by Most Probable Number of Enterobacteriaceae in food, animal and environmental products.
It is also recommended in the various harmonized Pharmacopeia for the detection of Gram negative bacteria that are resistant to bile salts.
Packaging
Dehydrated medium :
BK127HA – 500 g bottle
Elliker Broth

Elliker Broth, prepared according to the formula of Elliker, Anderson and Hannesson, contains the nutritive elements necessary for the growth of lactobacilli and lactic streptococci (including Lactococcus) in dairy products.
Packaging
Dehydrated medium :
BK054HA – 500 g bottle
EMB Agar (Levine)
EMB Agar, originally recommended by Levine, is used to isolate and identify enterobacteria (notably E. coli and Enterobacter aerogenes) in pharmaceutical, cosmetic and food products as well as water.
It is also used as a confirmation media for E. coli in cosmetic products.
Packaging
Dehydrated medium :
BK056HA – 500 g bottle
Endo Agar

Endo Agar is used for the confirmation of the presence of coliforms and/or thermotolerant coliforms in drinking water, in milk, in dairy products and in other foods.
Packaging
Dehydrated medium :
BK057HA – 500 g bottle
Ethyl Violet Azide (Litsky) Broth

Ethyl Violet Azide Broth (also known as Litsky broth) is used to carry out the confirmation test of the detection and enumeration of fecal streptococci (enterococci) in drinking water and waste water, in frozen foods and other food products by the most probable number method. The procedure involves two stages :
– presumptive test in Azide Dextrose Broth (Rothe)
– confirmation in Ethyl Violet Azide Broth (Litsky)
Packaging
Dehydrated medium :
BK061HA – 500 g bottle
Fraser Broth

Fraser broth is used for the selective secondary enrichment of Listeria monocytogenes and other Listeria in food products
Packaging
Ready-to-use medium:
BM01308 – 50 tubes of 10 mL
Dehydrated medium base (without ferric ammonium citrate):
BK115HA – 500 g bottle
Sterile solution of 5% ferric ammonium citrate:
BS05908 – 10 vials of 90 mL
BS06208 – 7 tubes of 10 mL
Dehydrated medium base II (without ferric ammonium citrate nor nalidixic acid nor acriflavin):
BK133HA – 500 g bottle
BK133GC – 5 kg drum
Freeze dried selective supplement (with ferric ammonium citrate, nalidixic acid and acriflavin):
BS03108 – 10 vials qsp 500 mL
Gentamicin 25 Mg Selective Supplement

Gentamicin 25 mg Selective Supplement is recommended to improve the isolation of yeasts and pathogenic fungi in clinical samples as well as for the enumeration of yeasts and molds in food products, particularly in meats and raw seafood. The selective supplement is composed of the antibiotic gentamicin.
Packaging
Freeze-dried supplement:
BS00908 – 10 vials
Giolitti & Cantoni Broth With Tween 80 (Base)

Giolitti and Cantoni Broth with Tween 80 is a selective enrichment medium for the detection and enumeration (particularly in low numbers) of coagulase positive staphylococci in food products.
Packaging
Ready-to-use medium (without potassium tellurite):
BM11008 – 50 tubes of 10 mL (single strength media)
BM11108 – 50 tubes of 10 mL (double strength media)
Dehydrated medium (without potassium tellurite):
BK159HA – 500 g bottle
Glucose Agar

Glucose agar allows the demonstration of glucose fermentation (with or without gas production) as an identification test for Enterobacteriaceae or Pseudomonas spp..
Packaging
Ready-to-melt medium :
BM09908 – 50 tubes of 10 mL
Glutamate Broth

Glutamate broth is used enumeration of β-glucuronidase positive E. coli in food products by the MPN technique. It is recommended when the microorganisms are found in a sub-optimal state due to exposition to stress including freezing, desiccation, disinfection or high salinity.
The described method does not allow the detection of strains of E. coli that do not develop at 44°C, and, in particular, those that are β-glucuronidase negative, as the case of E. coli O157 and a few other strains of pathogenic E. coli.
Packaging
Dehydrated medium:
BK186HA – 500 g bottle
Half Fraser Broth

Half Fraser broth is used for the selective and differential (primary enrichment broth) enrichment of Listeria monocytogenes and of Listeria spp in food products, according to the Standard NF EN ISO 11290-1.
The media is also used in the context of alternative rapid methods for the detection and enumeration of Listeria monocytogenes or Listeria spp.
Packaging
Ready-to-use medium:
BM01608 – 10 vials of 225 mL
BM13308 – 3 flexible bags of 3 L
BM13408 – 2 flexible bags of 5 L
BM18808 – 40 flexible bags of 5 L (carton)
Dehydrated media FRASER base II:
BK133HA – 500 g bottle
BK133GC – 5 kg drum
Dehydrated media complete Half-Fraser :
BK215HA – 500 g bottle
BK215GC – 5 kg drum
Half-Fraser + Tween® 80 (10g/L) ready-to-use media:
BM21208 – 3 flexible bags of 3 L
Half FRASER selective supplement:
BS03008 – 10 vials qsp 500 mL
BS03208 – 8 vials qsp 2,25 L
Half FRASER dehydrated media base (without ferric ammonium citrate):
BK173HA – 500 g bottle
BK173GC – 5 kg drum
Sterile 5% solution Ferric ammonium citrate:
BS05908 – 10 vials of 90 mL
BS06208 – 7 tubes of 10 mL
Hektöen Enteric Agar
Hektoen Enteric Agar is a selective medium for the isolation and differentiation of pathogenic enterobacteria from biological samples of animal origin, water samples, dairy products and other food products. It is used in animal health in the context of Salmonella detection in mammals.
The medium is also recommended for the detection of Shigella, in food microbiology.
Hektöen Enteric agar can also be used as the second media of choice in the standardized methods for the detection of Salmonella.
Packaging
Dehydrated medium :
BK067HA – 500 g bottle
Desoxycholate (0,1 %) Lactose Agar

Desoxycholate (0.1%) Lactose Agar is a selective medium for the enumeration of coliform bacteria in milk, dairy products and other food products. The medium is also recommended for the isolation and culture of Shigella.
Packaging
Dehydrated medium :
BK062HA – 500 g bottle
Iris Salmonella®
IRIS Salmonella® is an alternative research method of Salmonellae in human food and feeds, and environmental
sample (except primary production samples).
Studies performed on IRIS Salmonella® Agar show a high specificity for the detection of Salmonellae including
atypical species and serovars, which is a source of confusion on other medium.
Indeed, the detection of Salmonella Typhi and Paratyphi, lactose-positive Salmonellae (Salmonella Senftenberg and
subspecies S. arizonae and S. diarizonae), saccharose-positive strains are ensured.
The medium allows the detection of non-motile serovars (S. Pullorum and S. Gallinarum) or monophasic strains. IRIS
Salmonella® Agar allows also the detection of strains which show a light or absence of esterasic activity on other
medium (Salmonella bongori, Salmonella Dublin and Atento, certain strains of S. enterica, S. houtenae and S.
diarizonae subspecies).
The method is NF VALIDATION certified, with the IRIS Salmonella® supplement, according to the NF EN ISO 16140-
2 validation protocol of 2016 for the following categories:
– All food products (from 0 to 25 g)
– All animal feed and pet food (from 0 to 25 g), dry animal feed and pet food (from 50 g to 125 g)
– All samples from the industrial production environment
– Milk powders (including infant milk powders with and without probiotics) from 50 to 375 g
The method is also certified NF VALIDATION with the CSD supplement according to the validation protocol NF EN
ISO 16140-2 of 2016 for the following categories:
– Infant milk powders, with and without probiotics; ingredients for test intakes up to 50 g, with a 1/10th dilution
– Infant milk powders, with and without probiotics; ingredients for test intakes of 50-375 g, at 1/4 dilution
– Samples from the production environment
Refer to the certificate available on the NF VALIDATION website for the end date of validity of the method. The
reference method used for the validation is the standard NF EN ISO 6579-1 of 2017.
IRIS Salmonella® Agar may be used in the standard methods for the detection of Salmonellae as second isolation
medium.
The CSD supplement allows the common enrichment of Salmonella and Cronobacter in infant milk powders with
and without probiotics, ingredients, and environmental products.
Refer to the CSD method, BKR 23/12-12/20, certified NF VALIDATION, for the detection of Cronobacter spp
Packaging
IRIS Salmonella Agar:
BM16008 – 20 plates (Ø 90 mm)
BM16108 – 120 plates (Ø 90 mm)
Salmonella Enrichment:
BK194HA – 500 g bottle
BK194GC – 5 kg drum
BM13608 – 10 x 225 mL vials
BM13708 – 3 x 3 L flexible bag
BM14408 – 2 x 5 L flexible bag
BM23708 – 40 x 5 L flexible bag
Salmonella Enrichment + Tween® 80:
BM16308 – 3 x 3 L flexible bag
BM19808 – 2 x 5 L flexible bag
BM22808 – 10 x 225 mL bottles
Salmonella Enrichment 9X Concentrated:
BM23308 – 4 x 2.5 L flexible bag
IRIS Salmonella Supplement:
BS07808 – 10 x 50 mL vials
BS07708 – 120 tablets qsp 225 mL
BS09308 – 120 tablets qsp 90 mL
IRIS Salmonella concentrate Supplement:
BS10208 – 10 bottles of 90 mL
Latex agglutination test:
BT01108 – CONFIRM’ Salmonella
Iron Sulfite Agar (ISA) ISO 15213-1

The Iron Sulfite Agar (ISA) (ISO 15213-1) is recommended for the enumeration of sulfite-reducing Clostridium spp.
Sulfite-reducing Clostridium spp. are obligate anaerobic, Gram-positive, spore-forming, rod-shaped bacteria. The most important species which belong to this group are Clostridium, C. perfringens, C. bifermentans and C. sporogenes. Some species can cause foodborne illness. As ubiquitous bacteria they are predominantly found in nature. The Clostridium species inhabit soils and the intestinal tract of animals and humans.
Sulfite-reducing Clostridium spp., including C. perfringens, are widely used as microbial indicators of clostridial contamination in the manufacturing of foods (e.g. meat production). These have the capacity to produce heat-resistant spores.
The typical composition corresponds to that defined in the standard NF EN ISO 15213-1.
Packaging
Dehydrated media :
BK239HA – 500g bottle
Ready-to-melt media :
BM23508 – 10x200mL vials
KF Streptococcus Agar (Base)
KF (Kenner Fecal) Streptococcus Agar is a selective medium used for the isolation and enumeration of enterococci in food products by using classic enumeration techniques on Petri plates.
It is also recommended in the standard for the composition of acidifying lactic starters in dairy products, for the detection of enterococci as contaminants.
Packaging
Dehydrated medium :
BK132HA – 500 g bottle
Supplement TTC 50 mg :
BS02708 – 10 vials
Kligler Iron Agar

Kligler Iron Agar is used for the identification of enterobacteria by the rapid detection of lactose and glucose fermentation (with or without gas production), as well as the production of hydrogen sulfide.
Packaging
Dehydrated medium :
BK034HA – 500 g bottle
Lactose-Sulfite (LS) Broth

Lactose-Sulfite Broth is a confirmation medium allowing the selective detection of both the vegetative cells and spores of Clostridium perfringens in food products and biological samples of animal origin, without the usual confirmatory tests.
Packaging
Dehydrated medium:
BK140HA – 500 g bottle
Ready-to-use medium:
BM19208 – 7 tubes of 9 mL with Durham tube
Listeria Enrichment Broth (LEB Acc. To IDF)

LEB media (Listeria Enrichment Broth) according to the International Dairy Federation (IDF) is used for the selective enrichment of Listeria in milk and dairy products.
Packaging
Dehydrated medium :
BK124HA – 500 g bottle
Laurylsulfate-Tryptose Broth

Laurylsulfate-Tryptose broth is a selective enrichment media used for the detection and enumeration of E. coli and coliforms in water and food products.
The medium was formulated by Malmann and Darby who showed, in 1941, that sodium laurylsulfate was the best selective agent among a number of surfactants and did not inhibit the growth of coliforms bacteria. Levine later showed that the medium reduced the number of false positives by inhibiting the growth of sporulated gas-producing bacteria.
Packaging
Ready-to-use medium:
BM09708 – 50 tubes of 10 mL (simple strength with Durham tubes)
BM09808 – 50 tubes of 10 mL (double strength with Durham tubes)
Dehydrated medium:
BK010HA – 500 g bottle
Listeria Enrichment Broth (LEB Acc.To FDA)

LEB media according to FDA (Food and Drug Administration) is used for the selective enrichment of Listeria in milk, dairy products, meats, poultry and other food products.
Packaging
Dehydrated medium :
BK112HA – 500 g bottle
Listeria Enrichment Broth (Modified UVM I)

The enrichment broths UVM (University of Vermont) involve a 2 step process, leading to a higher degree of isolation of Listeria monocytogenes in meat products (including poultry).
UVM 1 enrichment broth allows for primary enrichment of Listeria.
Packaging
Dehydrated medium :
BK113HA – 500 g bottle
M 17 Agar

M17 Agar is used for the enumeration of lactococci (especially Lactococcus lactis) in dairy products. It is also used to study the sensitivity of these species to bacteriophages. It is well adapted to the enumeration of Streptococcus thermophiles in natural or flavored yogurts, textured or not, and in yogurts containing morsels of fruit.
Packaging
Dehydrated medium :
BK088HA – 500 g bottle
M 17 Agar

M17 Broth was developed for the growth and enumeration of lactic streptococci (lactococci) in milk and dairy products. It favors the growth of mutants unable to ferment lactose. It is well adapted to the culture of Lactococcus lactis (a particularly fastidious species).
Packaging
Dehydrated medium :
BK012HA – 500 g bottle
MacConkey Agar

MacConkey agar is a selective medium for the isolation of enterobacteria in water, food, pharmaceutical products and biological samples of animal origin and in cosmetic products.
Packaging
Ready-to-melt medium :
BM18008 – 10 vials of 100 mL
Dehydrated medium :
BK050HA – 500 g bottle
MacConkey Broth Purple

MacConkey Broth Purple complies with the formula described in the European Pharmacopoeia for the detection of E. coli in non-sterile products.
The media may be also used as a presumptive medium for the detection of coliform bacteria in water, milk, and seafood (oysters).
Packaging
Dehydrated medium :
BK107HA – 500 g bottle
MacConkey Sorbitol (CT-SMAC) Agar
MacConkey Sorbitol (CT-SMAC) agar is a selective media used for the isolation and differentiation of E. coli O157 in water, milk, beef products and other food preparations.
Packaging
Dehydrated base medium:
BK147HA – 500 g bottle
Cefixime-Tellurite Selective supplement:
BS03708 – 10 vials qsp 500 mL
Meat Liver Glucose 0,6% Agar

Meat-Liver Glucose 0.6% Agar is a medium specially designed for the growth and isolation of anaerobic bacteria growing in the depth of the medium. It can also be used to elucidate the type of bacterial respiration and is suitable for sterility tests of pharmaceutical products and canned foods.
Packaging
Dehydrated medium :
BK024HA – 500 g bottle
Meat Liver Glucose Agar With 2 G/L Yeast Extract

Meat Liver Glucose Agar with 2 g/L Yeast Extract is used to enumerate mesophilic and thermophilic anaerobic bacterial spores in raw materials and in ingredients used in canning as well as surface samples and canning process water.
It can also be used for the enumeration of spores in pasteurized products.
Packaging
Ready-to-use medium:
BM16908 – 10 vials of 200 mL
Meat-Yeast Agar

Meat-Yeast Agar is used to enumerate spores of sulfite-reducing anaerobic bacteria in gelatin and other food products.
The typical composition corresponds to that defined in the standard NF V59-106.
Packaging
Dehydrated medium :
BK006HA – 500 g bottle
Microgen Listeria-ID System

The Microgen Listeria-ID system allows the identification of six species of Listeria (Listeria monocytogenes, Listeria ivanovii, Listeria innocua, Listeria seeligeri, Listeria grayi, Listeria welshimeri).
They employs 12 standardised substrates include the haemolysis test.
The Microgen Identification System Software is available on demand.
Packaging
Microgen Listeria-ID system Kit:
BT01408 – Complete kit for 20 tests
Modified Laurylsulfate-Tryptose Vancomycine Broth (mLST/V)

Modified Laurylsulfate-Tryptose Vancomycin broth (mLST/V) is a selective enrichment medium used for the detection of Cronobacter sakazakii in milk and milk products.
Packaging
Ready-to-use medium:
BM12108 – 50 tubes of 10 mL
Dehydrated medium:
BK190HA – 500 g bottle